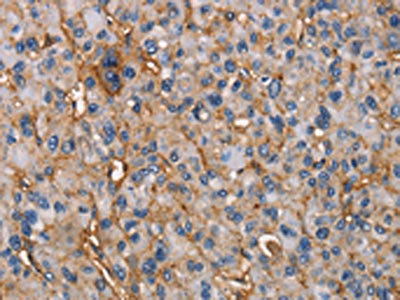

NT5E Antibody
-
中文名稱:NT5E兔多克隆抗體
-
貨號:CSB-PA823804
-
規格:¥1100
-
圖片:
-
The image on the left is immunohistochemistry of paraffin-embedded Human thyroid cancer tissue using CSB-PA823804(NT5E Antibody) at dilution 1/50, on the right is treated with fusion protein. (Original magnification: ×200)
-
The image on the left is immunohistochemistry of paraffin-embedded Human liver cancer tissue using CSB-PA823804(NT5E Antibody) at dilution 1/50, on the right is treated with fusion protein. (Original magnification: ×200)
-
-
其他:
產品詳情
-
Uniprot No.:
-
基因名:
-
別名:5' NT antibody; 5' nucleotidase (CD73) antibody; 5' nucleotidase precursor antibody; 5' nucleotidase; ecto antibody; 5' nucleotidase; ecto (CD73) antibody; 5'-NT antibody; 5'-nucleotidase antibody; 5NTD_HUMAN antibody; CD73 antibody; CD73 antigen antibody; E5NT antibody; Ecto 5' nucleotidase antibody; Ecto-5'-nucleotidase antibody; eN antibody; eNT antibody; NT antibody; NT5 antibody; NT5E antibody; NTE antibody; Purine 5 Prime Nucleotidase antibody
-
宿主:Rabbit
-
反應種屬:Human,Mouse,Rat
-
免疫原:Fusion protein of Human NT5E
-
免疫原種屬:Homo sapiens (Human)
-
標記方式:Non-conjugated
-
抗體亞型:IgG
-
純化方式:Antigen affinity purification
-
濃度:It differs from different batches. Please contact us to confirm it.
-
保存緩沖液:-20°C, pH7.4 PBS, 0.05% NaN3, 40% Glycerol
-
產品提供形式:Liquid
-
應用范圍:ELISA,IHC
-
推薦稀釋比:
Application Recommended Dilution ELISA 1:1000-1:5000 IHC 1:50-1:200 -
Protocols:
-
儲存條件:Upon receipt, store at -20°C or -80°C. Avoid repeated freeze.
-
貨期:Basically, we can dispatch the products out in 1-3 working days after receiving your orders. Delivery time maybe differs from different purchasing way or location, please kindly consult your local distributors for specific delivery time.
-
用途:For Research Use Only. Not for use in diagnostic or therapeutic procedures.
相關產品
靶點詳情
-
功能:Hydrolyzes extracellular nucleotides into membrane permeable nucleosides. Exhibits AMP-, NAD-, and NMN-nucleosidase activities.
-
基因功能參考文獻:
- Changes in the local expression and activity of CD39 and CD73 in calcified valves suggest their potential role in calcific aortic valve disease. PMID: 30056298
- High expression of NT5E is associated with Prostate Cancer. PMID: 29916747
- Case Report: identify novel mutations in the NT5E gene in patient with calcification of joints and arteries. PMID: 28825389
- High CD73 expression is associated with breast cancer. PMID: 29047106
- High CD73 expression is associated with neoplasms. PMID: 29514610
- NT5E-targeting miRNAs (miR-30b and miR-340) function as tumor suppressors PMID: 29155108
- soluble CD73 might be used as serologic prognostic biomarker in patients with metastatic melanoma patients. PMID: 29202855
- High CD73 expression is associated with the increase in the ability of surviving breast cancer cells to evade innate and adaptive immunity. PMID: 29367423
- analysis of how inhibitors block human CD73 and block efficiently its enzymatic function in the low micromolar range through a non-competitive inhibition mechanism PMID: 29377887
- The Ecto-5'nucleotidase, together with alkaline phosphatase, also expressed apically in oviductal epithelium, complete the hydrolysis sequence by dephosphorylating AMP to adenosine. PMID: 29273916
- this paper shows that simultaneous overexpression of human E5NT and ENTPD1 protects porcine endothelial cells against H2O2-induced oxidative stress and cytotoxicity in vitro PMID: 28389406
- high levels of CD73 are significantly associated with reduced overall survival in patients with head and neck squamous cell carcinoma PMID: 27557512
- Studied role of miR-30a in colorectal cancer(CRC). Found miR-30a is downregulated in CRC, and it inhibits cell proliferation in CRC by reducing expression of CD73. PMID: 28464916
- we demonstrated the existence of CSCs in both cultured ccRCC cell line and tissues, and CD73 as a cell-surface biomarker for ccRCC CSC-like cells. PMID: 28404888
- Induction of ecto-5'-nucleotidase/CD73 by radiation contributes to the radiosensitivity of T24 urinary bladder cancer cell line. PMID: 29305710
- Report prognostic impact of CD73 expression in non-small lung cancers. PMID: 28060732
- Data show that MiR-422a and its target CD73 are involved in early loco(regional) recurrence of head and neck squamous cell carcinoma (HNSCC) tumors and are targets for personalized medicine. PMID: 27281619
- HPV+ cervical cancer cells express higher levels of CD73 than HPV- cells, and this expression is associated with the production of larger amounts of adenosine, as well as a stronger inhibition of proliferation, activation, and cytotoxic activity of CD8+ T cells via interaction with A2A adenosine receptor PMID: 28950987
- High CD73 expression is associated with Melanoma Metastasis. PMID: 28652244
- Hippocampal astrogliosis observed in medial temporal lobe epilepsy patients was accompanied by a proportionate increase in A2A receptor and ecto-5'-nucleotidase/CD73 immunoreactivities. PMID: 27650530
- High CD73 expression is associated with cervical cancer. PMID: 28202050
- Endogenous Plastic Somatic (ePS) cells in a latent state, i.e. lacking SOX2, OCT3/4 and NANOG (SON) expression, in non-diseased breast specimens through immunohistochemical analysis of previously identified ePS-specific biomarkers (CD73(+), EpCAM(+) and CD90(-)). PMID: 27705752
- Down-regulation of CD73 on B cells of patients with viremic HIV correlates with B cell activation and disease progression. PMID: 28193736
- CD73 polymorphisms play a role in calciphylaxis development in dialysis patients. PMID: 28212442
- CD73 expression is upregulated in NSCLC and is correlated with a decrease in miR-30a-5p expression. PMID: 28158983
- This study found that in septic critically ill patients the soluble CD73 levels were generally low and showed a further decrease from 0h to 24h. Moreover, the sCD73 levels were higher in acute kidney injury (AKI) versus non-AKI patients and in non-survivors with severe sepsis than in survivors, but were not independently associated either with the development of AKI or 90-day mortal PMID: 27732656
- concluded that CD39 and CD73 are molecular targets for the development of drugs for ALF patients care PMID: 27899277
- Genetic polymorphism of NT5E may contribute to the pathogenesis of calcific aortic valve disease. PMID: 27906615
- Oxidized low density lipoproteins modulate CD39 and CD73 activity in the endothelium. PMID: 27906627
- CD73 may play an important role in breast cancer stem cells. PMID: 27670764
- This study aimed to investigate the activities of purinergic system ecto-enzymes present on the platelet surface as well as CD39 and CD73 expressions on platelets of sickle cell anemia treated patients. PMID: 27044834
- Aim of the present study was to investigate the role of CD73 in glioma blood vessels; results found that the expression of CD73 in glioma vascular cells is significantly decreased, and this reduction may down-regulate the expression of brain microvascular endothelial tight junction-related proteins PMID: 26884147
- These results provide a finely mapped epitope that can be targeted for selective, potent, and non-competitive inhibition of CD73, as well as establish a strategy for inhibiting enzymes that function in both membrane-bound and soluble states. PMID: 26854859
- CD73 promotes the growth of human colorectal cancer cells through EGFR and the b-catenin/cyclin D1 signaling pathway. CD73 may be used as a valuable biomarker of colorectal cancer. PMID: 26708311
- Our study revealed that CD73 is an independent prognostic factor in prostate cancer. PMID: 26253870
- The NT5E gene is involved in both intrinsic and acquired resistance to platinum-based drugs in ovarian cancer. [meta-analysis] PMID: 26629888
- CD73 expression was significantly correlated with the invasion into adjacent organs. PMID: 26691441
- report on a Chinese family with CALJA and novel compound heterozygous mutations (c.1360G>A (p.Gly454Arg) and c.1387C>T (p.Arg463X)) in NT5E PMID: 26178434
- findings reveal that CD73-generated adenosine promotes epithelial integrity and suggest why loss of CD73 in endometrial cancer allows for tumor progression PMID: 26642367
- CD73 activity from any host cell type is not required for the monocyte/macrophage polarization in the peritoneum towards a pro- or an anti-inflammatory phenotype in vivo PMID: 26258883
- these data suggest a possible role for CD73 and A2A in inflammation observed in patients with T2D and obesity mediated via apoptosis. PMID: 25770019
- This study highlights a role for CD73 as a prognostic marker of patient survival and also as a candidate therapeutic target in high-grade serous ovarian cancers. PMID: 26363007
- role of CD73 and CD39 ectonucleotidases in T cell differentiation PMID: 26226423
- Expression of NPP1 and 5'-nucleotidase by valve interstitial cells promotes the mineralization of the aortic valve through A2aR and a cAMP/PKA/CREB pathway. PMID: 25644539
- Although upregulated CD73 expression in tumor cells correlates with a poor prognosis in patients with rectal adenocarcinoma, the combination of CD73 expression in malignant epithelial cells and tumor stroma may have a better prognostic value PMID: 25677906
- rs9444348 heterozygosity is associated with increased risk of post-traumatic epilepsy development after brain injury. PMID: 26040919
- Species-specific CD73 regulation, with potential significance to cancer, fibrosis, and other diseases characterized by changes in CD73 expression and function. PMID: 25298403
- The Nt5e(-/-) targeted mutant mice recapitulate some, but not all, features of ACDC and serve as a model system to study pharmacologic interventions for ectopic mineralization. PMID: 25486201
- CD73 enhances endothelial barrier function and sprouting in blood but not lymphatic vasculature. PMID: 25402681
- It decompose ATP and produce adenosine, which regulates immunity via adenosine receptor. PMID: 25675814
顯示更多
收起更多
-
相關疾?。?/div>Calcification of joints and arteries (CALJA)亞細胞定位:Cell membrane; Lipid-anchor, GPI-anchor.蛋白家族:5'-nucleotidase family數據庫鏈接:
Most popular with customers
-
-
Phospho-YAP1 (S127) Recombinant Monoclonal Antibody
Applications: ELISA, WB, IHC
Species Reactivity: Human
-
-
-
-
-
-